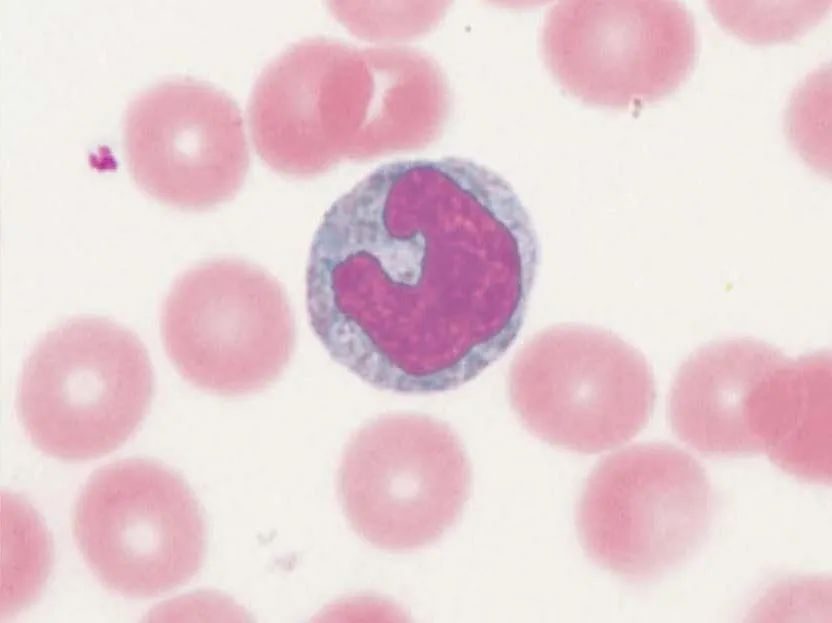
图片

8 年
手机商铺
公司新闻/正文
453 人阅读发布时间:2025-05-21 14:57
空间分辨代谢组学是近年来崛起的前沿分析技术,它创新性地融合了质谱成像(Mass Spectrometry Imaging, MSI)与代谢组学方法。其中,质谱成像技术能够精准识别并定位组织乃至细胞间多种代谢物的差异性分布,以可视化方式呈现代谢物的空间分布特征;而代谢组学则可针对目标微区域组织开展深度分析,系统获取代谢物的种类及含量信息。这种技术整合不仅实现了代谢物空间定位与定量分析的有机结合,更能从“空间-分子”双维度揭示生物样本中代谢网络的异质性,为解析疾病发生发展的分子机制、探索新型生物标志物等领域提供了突破性的研究工具。

空间分辨代谢组学技术
空间分辨代谢组学技术的来源
空间分辨代谢组学(Spatially resolved metabolomics)一词最早于2007年由Sumner课题组在美国植物学联合年会上提出,当时主要是利用激光切割显微镜技术结合代谢组学手段来进行代谢物在组织层面的分辨。从2010年开始,科学家们才真正将MSI技术引入到植物组织的代谢组学研究中。2019年,研究者们利用基于MSI的空间代谢组学技术分别对人鳞片状食管癌组织中代谢相关的差异代谢物和植物单细胞中功能代谢物进行空间定位。进一步将空间分辨代谢组学技术从植物领域拓展到了动物组织甚至单细胞领域。得益于质谱仪器成像分辨率和检测灵敏度的提高,空间分辨代谢组学突破了传统代谢组学信息深度不足的缺点,将组学信息拓展到了二维水平,极大地提升了对样品信息的认知。
质谱成像技术以其无需探针标记、非特异性检测、可一次分析同时获得数百个代谢物分子的成像等优势,可直接捕获目标代谢物在动/植物组织中的空间分布,为代谢组学分析提供了一种新的研究手段。
空间分辨代谢组学技术的前沿应用
动物组织
空间分辨代谢组学在动物组织中的应用主要是研究肿瘤组织代谢通路、监测外源性药物分子在组织内的吸收(Absorption)、分布(Distribution)、代谢(Metabolism)和排泄(Excretion)即 ADME过程、候选药物评价等。

植物组织
空间分辨代谢组学在植物组织中的应用主要是代谢物的精准定位、重要功能代谢产物的生物合成和转运途径、功能基因验证等。

单细胞水平
空间分辨代谢组学在单细胞中的应用主要是内源性代谢物和外源性药物分布、功能性代谢物的生物合成过程监测、纳米载药诱导癌细胞凋亡等。
空间分辨代谢组学作为生命科学领域的前沿技术,能精准解析代谢物在组织、细胞水平的空间分布与含量差异,为疾病机制研究、药物靶点发现、生物标志物筛选等提供关键数据支撑。我们拥有专业的技术团队与先进的质谱成像设备,可提供从样本制备、数据采集到深度分析的一站式服务,涵盖肿瘤异质性研究、神经退行性疾病代谢图谱绘制等多领域应用。无论您是科研机构、药企,还是创新型企业,若您需要挖掘空间代谢组学的潜在价值,欢迎随时联系我们,我们将根据您的需求定制个性化解决方案,助力科研与产业突破。